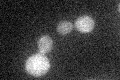
YGR068C
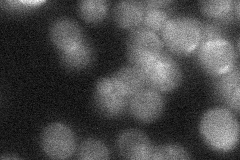
YGR068C

View description
Protein proposed to regulate the endocytosis of plasma membrane proteins by recruiting the ubiquitin ligase Rsp5p to its target in the plasma membrane
Localization:
Intensity:
Fold change:
Significance:
-
C’ GFP library in SD
cytosol23.77 -
N' NOP1pr-GFP in SD

cytosol48.0679 -
N' TEF2pr-mCherry in SD

cytosol63.1451 -
N' NATIVEpr-GFP in SD
below threshold21.1716 -
N' TEF2pr-VC and Cyto-VN in SD

cytosol31.1081 -
C’ GFP library in SD+DTT

cytosol23.480.98No -
C’ GFP library in SD+H2O2

cytosol24.741.04No -
C’ GFP library in Starvation Media

cytosol19.710.82No -
C’ GFP library on the background of Pup2-DaMP

cytosol -
C’ GFP library on the background of CCT mutant

cytosol24.03971.0108No
